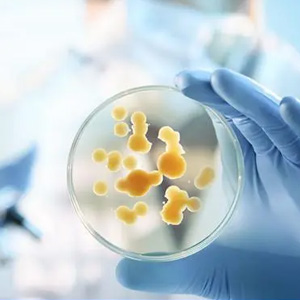

食品科學(xué)技術(shù)研究院
食品科學(xué)技術(shù)研究院主要從事農(nóng)副產(chǎn)品保鮮、貯藏、加工的研究開(kāi)發(fā)與工程技術(shù)服務(wù),下設(shè)果蔬研究所、主食研究所、肉類研究所,擁有柑桔加工中試車間、肉類中試車間,飲料中試車間等,研究和中試設(shè)備,設(shè)施完善,掛靠有“川西平原生態(tài)大蒜(產(chǎn)業(yè)化)研究中心”、“四川牦牛乳技術(shù)研究開(kāi)發(fā)中心”,與企業(yè)共建有5個(gè)工程技術(shù)(研究開(kāi)發(fā))中心,擁有長(zhǎng)期工作在第一線、實(shí)踐經(jīng)驗(yàn)豐富的高、中級(jí)工程技術(shù)人員19人,承擔(dān)并完成多項(xiàng)國(guó)家部省級(jí)科研項(xiàng)目,獲國(guó)家、省、市科技獎(jiǎng)10多項(xiàng),出版果蔬為主的農(nóng)產(chǎn)品加工食品專著10多部,發(fā)表論文100多...